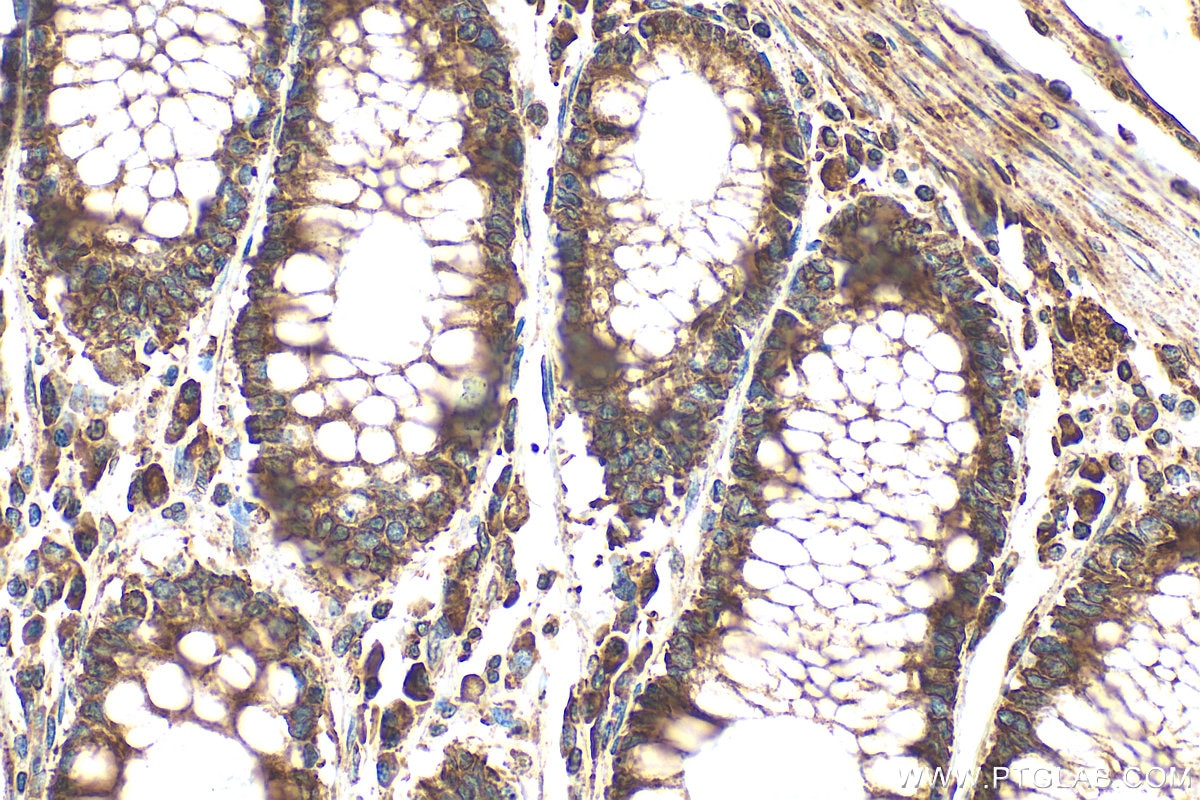
Immunohistochemistry (IHC) staining of human colon tissue using PRKCSH Polyclonal antibody (12148-1-AP)

Validation Data Gallery
Tested Applications
Recommended dilution
| Application | Dilution |
|---|---|
| It is recommended that this reagent should be titrated in each testing system to obtain optimal results. | |
Product Information
12148-1-PBS targets PRKCSH in WB, IHC, IF/ICC, IP, Indirect ELISA applications and shows reactivity with human, mouse, rat samples.
| Tested Reactivity | human, mouse, rat |
| Host / Isotype | Rabbit / IgG |
| Class | Polyclonal |
| Type | Antibody |
| Immunogen |
CatNo: Ag2796 Product name: Recombinant human PRKCSH protein Source: e coli.-derived, PGEX-4T Tag: GST Domain: 157-506 aa of BC013586 Sequence: TVKEEAEKPEREAKEQHQKLWEEQLAAAKAQQEQELAADAFKELDDDMDGTVSVTELQTHPELDTDGDGALSEAEAQALLSGDTQTDATSFYDRVWAAIRDKYRSEALPTDLPTPSAPDLTEPKEEQPPVPSSPTEEEEEEEEEEEEAEEEEEEEDSEEAPPPLSPPQPASPAEEDKMPPYDEQTQAFIDAAQEARNKFEEAERSLKDMEESIRNLEQEISFDFGPNGEFAYLYSQCYELTTNEYVYRLCPFKLVSQKPKLGGSPTSLGTWGSWIGPDHDKFSAMKYEQGTGCWQGPNRSTTVRLLCGKETMVTSTTEPSRCEYLMELMTPAACPEPPPEAPTEDDHDEL 相同性解析による交差性が予測される生物種 |
| Full Name | protein kinase C substrate 80K-H |
| Calculated molecular weight | 80 kDa |
| Observed molecular weight | 80 kDa |
| GenBank accession number | BC013586 |
| Gene Symbol | PRKCSH |
| Gene ID (NCBI) | 5589 |
| RRID | AB_2253107 |
| Conjugate | Unconjugated |
| Form | |
| Form | Liquid |
| Purification Method | Antigen affinity purification |
| UNIPROT ID | P14314 |
| Storage Buffer | PBS only{{ptg:BufferTemp}}7.3 |
| Storage Conditions | Store at -80°C. |
Background Information
PRKCSH encodes the beta-subunit of glucosidase II, an N-linked glycan-processing enzyme in the endoplasmic reticulum (ER). This protein is an acidic phospho-protein known to be a substrate for protein kinase C. Defects in PRKCSH are a cause of an autosomal dominant polycystic liver disease (PCLD). Glucosidase II is an ER-localized enzyme that contains α and β subunits (Glucosidase IIα and Glucosidase IIβ) which form a defined heterodimeric complex.